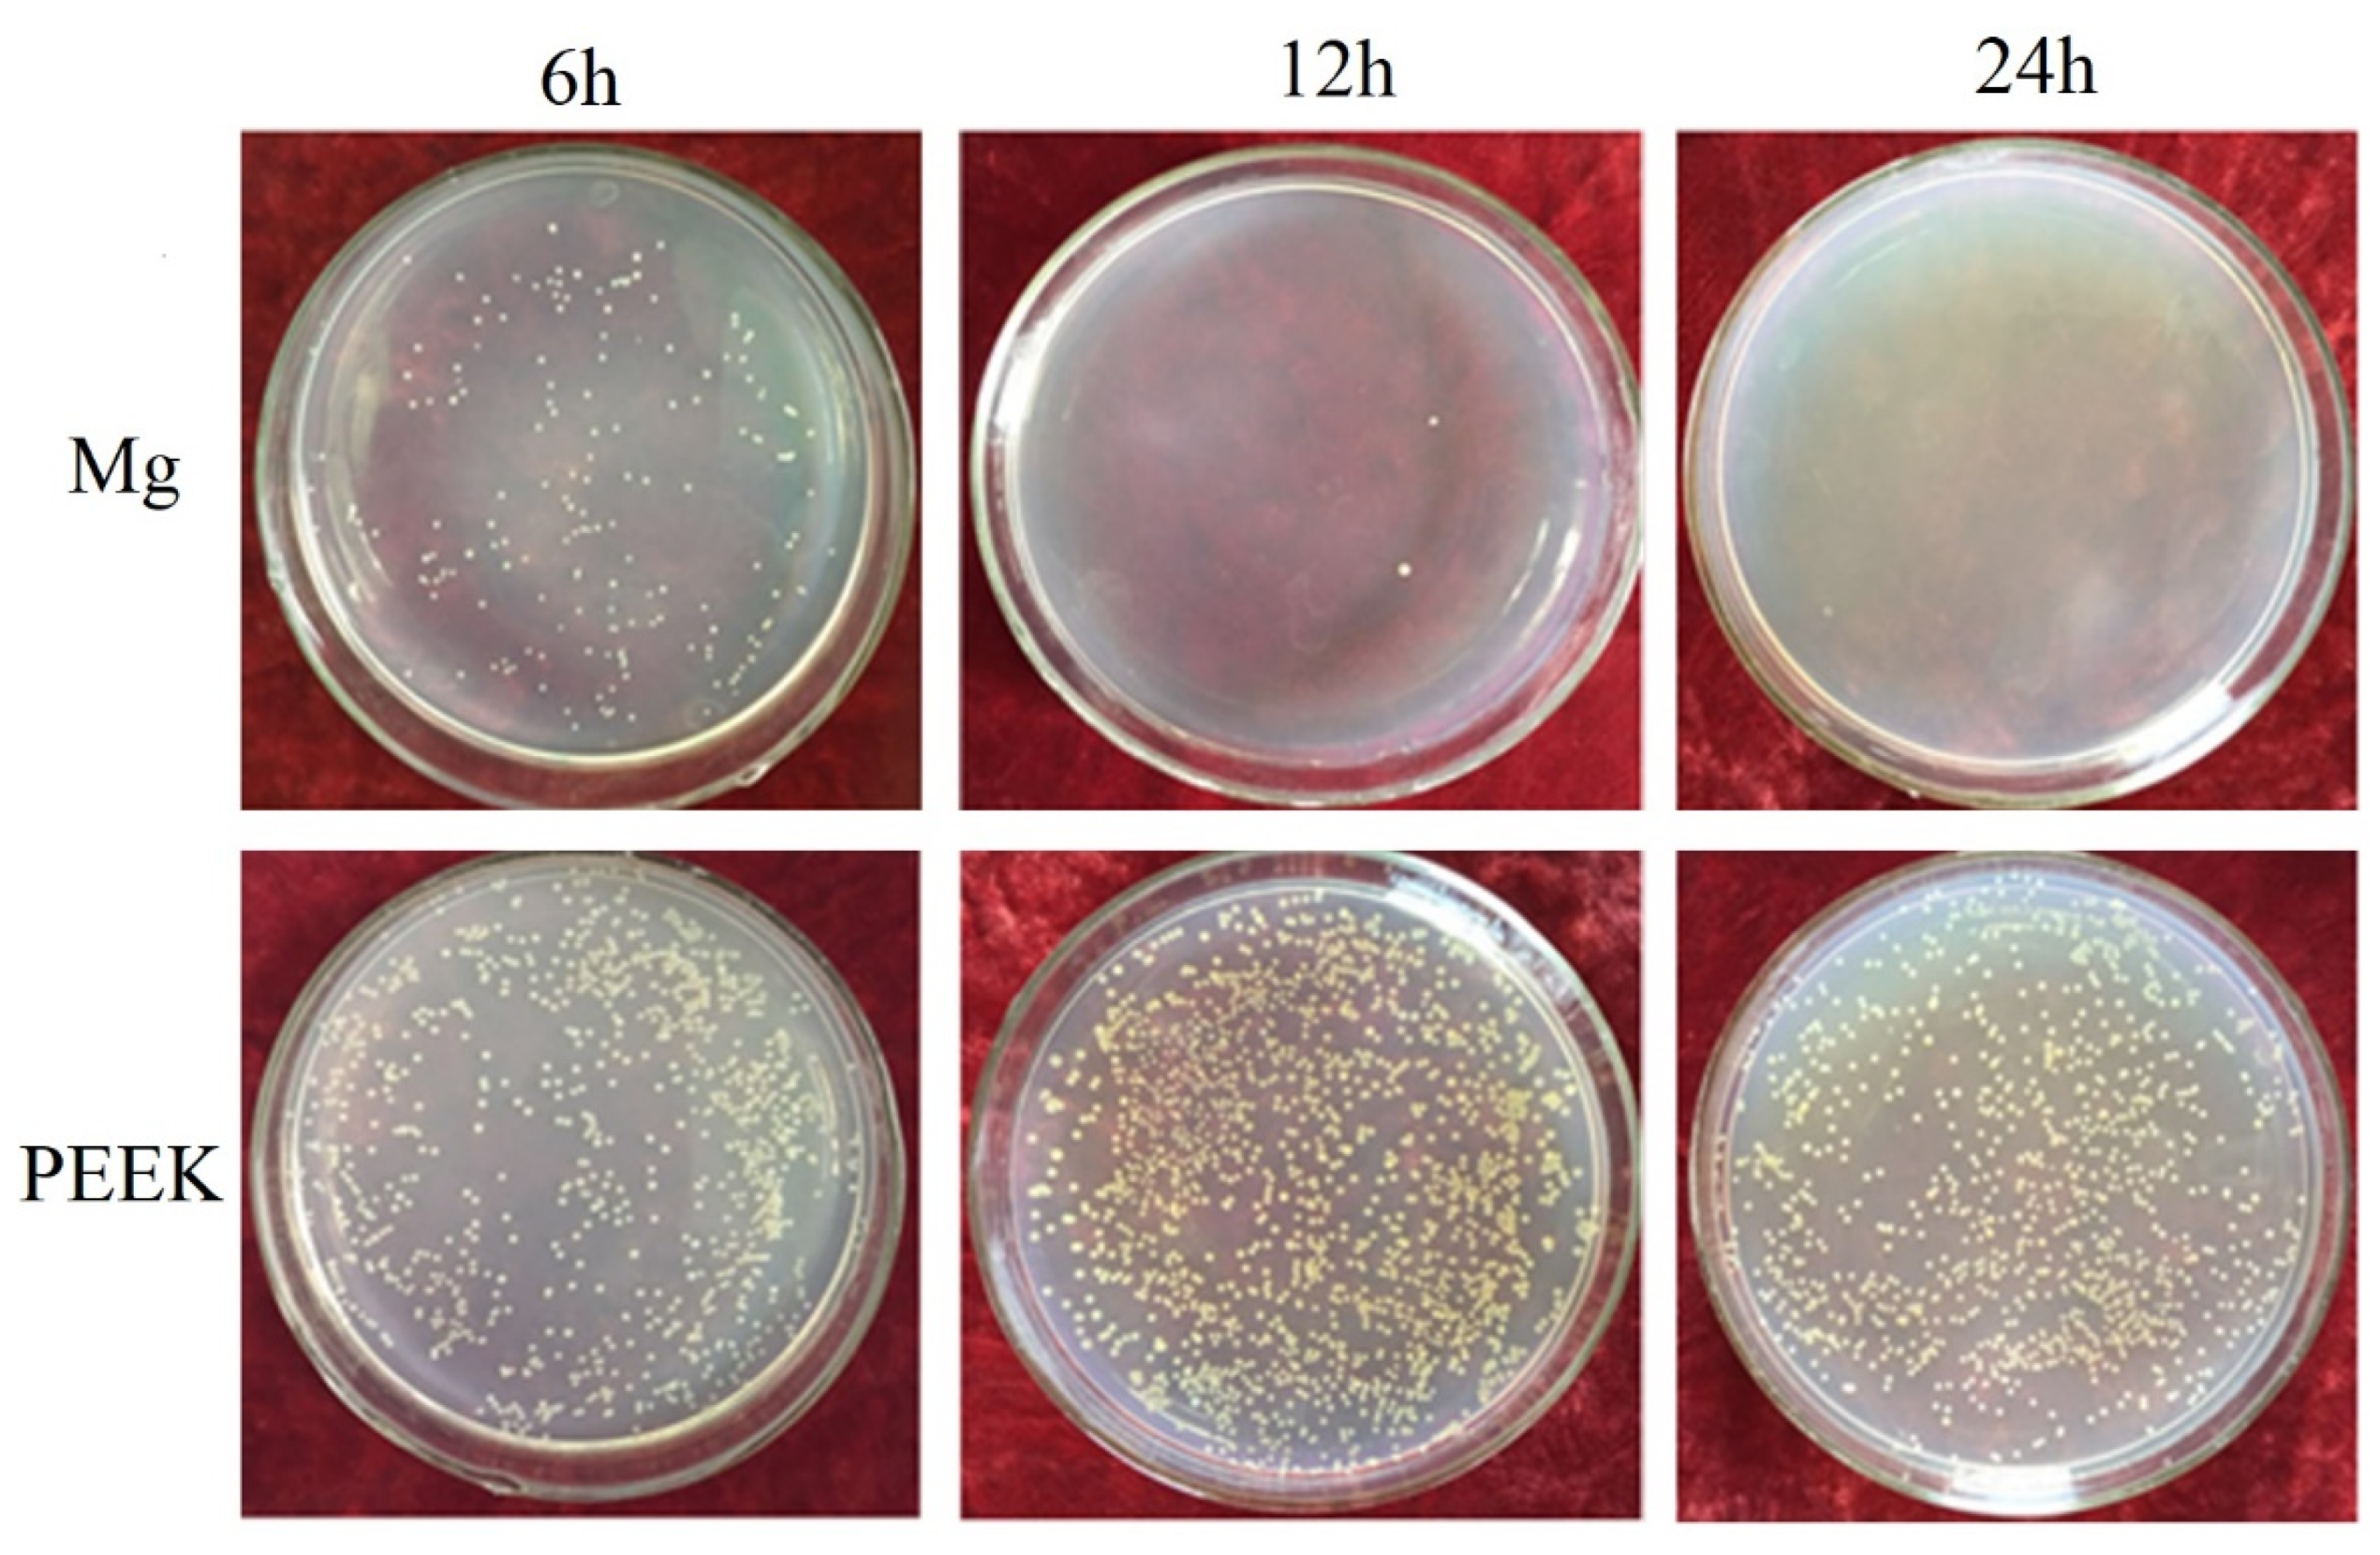
Coatings 11 01010 g007 Coatings 11 01010 g007

Fabrication of Mg Coating on PEEK and Antibacterial Evaluation for Bone Application
Abstract
:1. Introduction
2. Materials and Methods
2.1. Materials and Coating
2.2. Immersion Test
2.3. Antibacterial Test
3. Results and Discussion
3.1. Morphology of the Mg Coating
3.2. Surface Roughness of the Mg Coating and the PEEK Substrate
3.3. Wettability and Surface Free Energy of Mg Coating
3.4. Degradation Behavior of Mg Coating
3.5. Antibacterial Properties of Mg Coating
4. Conclusions
Author Contributions
Funding
Institutional Review Board Statement
Informed Consent Statement
Data Availability Statement
Conflicts of Interest
References
- Kurtz, S.M.; Devine, J.N. PEEK biomaterials in trauma, orthopedic, and spinal implants. Biomaterials 2007, 28, 4845–4869. [Google Scholar] [CrossRef] [PubMed] [Green Version]
- Li, S.; Wang, T.; Hu, J.; Li, Z.; Wang, B.; Wang, L.; Zhou, Z. Surface porous poly-ether-ether-ketone based on three-dimensional printing for load-bearing orthopedic implant. J. Mech. Behav. Biomed. Mater. 2021, 120, 104561. [Google Scholar] [CrossRef]
- Gao, C.; Wang, Z.; Jiao, Z.; Wu, Z.; Guo, M.; Wang, Y.; Liu, J.; Zhang, P. Enhancing antibacterial capability and osseointegration of polyetheretherketone (PEEK) implants by dual-functional surface modification. Mater. Des. 2021, 205, 109733. [Google Scholar] [CrossRef]
- Haleem, A.; Javaid, M. Polyether ether ketone (PEEK) and its 3D printed implants applications in medical field: An overview. Clin. Epidemiol. Glob. Health 2019, 7, 571–577. [Google Scholar] [CrossRef] [Green Version]
- Oladapo, B.I.; Zahedi, S.A.; Ismail, S.O.; Omigbodun, F.T. 3D printing of PEEK and its composite to increase biointerfaces as a biomedical material- A review. Colloids Surf. B Biointerfaces 2021, 203, 111726. [Google Scholar] [CrossRef]
- Pace, N.; Marinelli, M.; Spurio, S. Technical and Histologic Analysis of a Retrieved Carbon Fiber–Reinforced Poly-Ether-Ether-Ketone Composite Alumina-Bearing Liner 28 Months after Implantation. J. Arthroplast. 2008, 23, 151–155. [Google Scholar] [CrossRef]
- Schwitalla, A.D.; Spintig, T.; Kallage, I.; Müller, W.D. Pressure behavior of different PEEK materials for dental implants. J. Mech. Behav. Biomed. Mater. 2016, 54, 295–304. [Google Scholar] [CrossRef]
- Wu, X.; Liu, X.; Wei, J.; Ma, J.; Deng, F.; Wei, S. Nano-TiO2/PEEK bioactive composite as a bone substitute material: In vitro and in vivo studies. Int. J. Nanomed. 2012, 7, 1215–1225. [Google Scholar]
- Yu, S.; Hariram, K.P.; Kumar, R.; Cheang, P.; Aik, K.K. In vitro apatite formation and its growth kinetics on hydroxyapatite/polyetheretherketone biocomposites. Biomaterials 2005, 26, 2343–2352. [Google Scholar] [CrossRef]
- Manzoor, F.; Golbang, A.; Jindal, S.; Dixon, D.; McIlhagger, A.; Harkin-Jones, E.; Crawford, D.; Mancuso, E. 3D printed PEEK/HA composites for bone tissue engineering applications: Effect of material formulation on mechanical performance and bioactive potential. J. Mech. Behav. Biomed. Mater. 2021, 121, 104601. [Google Scholar] [CrossRef]
- Ma, H.; Suonan, A.; Zhou, J.; Yuan, Q.; Liu, L.; Zhao, X.; Lou, X.; Yang, C.; Li, D.; Zhang, Y.G. PEEK (Polyether-ether-ketone) and its composite materials in orthopedic implantation. Arab. J. Chem. 2021, 14, 102977. [Google Scholar] [CrossRef]
- Oladapo, B.I.; Zahedi, S.A. Improving bioactivity and strength of PEEK composite polymer for bone application. Mater. Chem. Phys. 2021, 266, 124485. [Google Scholar] [CrossRef]
- Lu, T.; Liu, X.; Qian, S.; Cao, H.; Qiao, Y.; Mei, Y.; Chu, P.K.; Ding, C. Multilevel surface engineering of nanostructured TiO2 on carbon-fiber-reinforced polyetheretherketone. Biomaterials 2014, 35, 5731–5740. [Google Scholar] [CrossRef]
- Sargin, F.; Erdogan, G.; Kanbur, K.; Turk, A. Investigation of in vitro behavior of plasma sprayed Ti, TiO2 and HA coatings on PEEK. Surf. Coat. Technol. 2021, 411, 126965. [Google Scholar] [CrossRef]
- Xian, P.; Chen, Y.; Gao, S.; Qian, J.; Zhang, W.; Udduttula, A.; Huang, N.; Wan, G. Polydopamine (PDA) mediated nanogranular-structured titanium dioxide (TiO2) coating on polyetheretherketone (PEEK) for oral and maxillofacial implants application. Surf. Coat. Technol. 2020, 401, 126282. [Google Scholar] [CrossRef]
- Suska, F.; Omar, O.; Emanuelsson, L.; Taylor, M.; Gruner, P.; Kinbrum, A.; Hunt, D.; Hunt, T.; Taylor, A.; Palmquist, A. Enhancement of CRF-PEEK osseointegration by plasma-sprayed hydroxyapatite: A rabbit model. J. Biomater. Appl. 2014, 29, 234–242. [Google Scholar] [CrossRef]
- Kashii, M.; Kitaguchi, K.; Makino, T.; Kaito, T. Comparison in the same intervertebral space between titanium-coated and uncoated PEEK cages in lumbar interbody fusion surgery. J. Orthop. Sci. 2020, 25, 565–570. [Google Scholar] [CrossRef] [PubMed]
- Lu, T.; Wen, J.; Qian, S.; Cao, H.; Ning, C.; Pan, X.; Jiang, X.; Liu, X.; Chu, P.K. Enhanced osteointegration on tantalum-implanted polyetheretherketone surface with bone-like elastic modulus. Biomaterials 2015, 51, 173–183. [Google Scholar] [CrossRef]
- Mei, S.; Yang, L.; Pan, Y.; Wang, D.; Wang, X.; Tang, T.; Wei, J. Influences of tantalum pentoxide and surface coarsening on surface roughness, hydrophilicity, surface energy, protein adsorption and cell responses to PEEK based biocomposite. Colloids Surf. B Biointerfaces 2019, 174, 207–215. [Google Scholar] [CrossRef] [PubMed]
- Lyu, H.; Jiang, N.; Li, Y.; Zhang, D. Enhancing CF/PEEK interfacial adhesion by modified PEEK grafted with carbon nanotubes. Compos. Sci. Technol. 2021, 210, 108831. [Google Scholar] [CrossRef]
- Chen, L.; Fu, X.; Pan, H.; Peng, W.; Lei, W.; Tan, L.; Wang, K.; Ying, Z.; Ke, Y.; Chu, P.K. Biodegradable Mg-Cu alloys with enhanced osteogenesis, angiogenesis, and long-lasting antibacterial effects. Sci. Rep. 2016, 6, 27374. [Google Scholar]
- Chen, Z.; Mao, X.; Tan, L.; Friis, T.; Wu, C.; Crawford, R.; Xiao, Y. Osteoimmunomodulatory properties of magnesium scaffolds coated with β-tricalcium phosphate. Biomaterials 2014, 35, 8553–8565. [Google Scholar] [CrossRef]
- Zhai, Z.; Qu, X.; Li, H.W.; Ke, Y.; Peng, W.; Tan, L.; Ouyang, Z.X.; Liu, X.Q.; Dai, K.R. The effect of metallic magnesium degradation products on osteoclast-induced osteolysis and attenuation of NF-κB and NFATc1 signaling. Biomaterials 2014, 35, 6299–6310. [Google Scholar] [CrossRef]
- Cheng, M.Q.; Wahafu, T.; Jiang, G.F.; Liu, W.; Qiao, Y.Q.; Peng, X.C.; Cheng, T.; Zhang, X.L.; He, G.; Liu, X.Y. A novel open-porous magnesium scaffold with controllable microstructures and properties for bone regeneration. Sci. Rep. 2016, 6, 24134. [Google Scholar] [CrossRef] [PubMed] [Green Version]
- Zhao, D.; Witte, F.; Lu, F.; Wang, J.; Li, J.; Qin, L. Current status on clinical applications of magnesium-based orthopaedic implants: A review from clinical translational perspective. Biomaterials 2016, 17, 287–302. [Google Scholar] [CrossRef] [PubMed]
- Tan, L.; Yu, X.; Wan, P.; Yang, K. Biodegradable Materials for Bone Repairs: A Review. J. Mater. Sci. Technol. 2013, 29, 503–513. [Google Scholar] [CrossRef]
- Wang, Q.; Jin, S.; Lin, X.; Zhang, Y.; Ren, L.; Yang, K. Cytotoxic Effects of Biodegradation of Pure Mg and MAO-Mg on Tumor Cells of MG63 and KB. J. Mater. Sci. Technol. 2014, 30, 487–492. [Google Scholar] [CrossRef]
- Qu, X.; Jin, F.; Hao, Y.; Zhu, Z.; Li, H.; Tang, T.; Dai, K. Nonlinear association between magnesium intake and the risk of colorectal cancer. Eur. J. Gastroenterol. Hepatol. 2013, 25, 309–318. [Google Scholar] [CrossRef] [PubMed]
- Li, M.; Ren, L.; Li, L.H.; He, P.; Lan, G.B.; Zhang, Y.; Yang, K. Cytotoxic Effect on Osteosarcoma MG-63 Cells by Degradation of Magnesium. J. Mater. Sci. Technol. 2014, 30, 888–893. [Google Scholar]
- Robinson, D.A.; Griffith, R.W.; Dan, S.; Evans, R.B.; Conzemius, M.G. In vitro antibacterial properties of magnesium metal against Escherichia coli, Pseudomonas aeruginosa and Staphylococcus aureus. Acta Biomater. 2009, 6, 1869–1877. [Google Scholar] [CrossRef]
- Ren, L.; Lin, X.; Tan, L.; Yang, K. Effect of surface coating on antibacterial behavior of magnesium based metals. Mater. Lett. 2011, 65, 3509–3511. [Google Scholar] [CrossRef]
- Li, Y.; Liu, G.; Zhai, Z.; Liu, L.; Li, H.; Yang, K.; Tan, L.; Wan, P.; Liu, X.; Ouyang, Z. Antibacterial properties of magnesium in an in vitro and in vivo model of implant-associated MRSA infection. Antimicrob. Agents Chemother. 2014, 58, 7586–7591. [Google Scholar] [CrossRef] [Green Version]
- Cui, L.-Y.; Ji, X.U.; Na, L.U.; Zeng, R.-C.; Zou, Y.H.; Li, S.-Q.; Zhang, F. In vitro corrosion resistance and antibacterial properties of layer-by-layer assembled chitosan/poly-L-glutamic acid coating on AZ31 magnesium alloys. Trans. Nonferrous Met. Soc. China 2017, 27, 1081–1086. [Google Scholar] [CrossRef]
- Liu, L.; Li, P.; Zou, Y.; Luo, K.; Zhang, F.; Zeng, R.C.; Li, S. In vitro corrosion and antibacterial performance of polysiloxane and poly(acrylic acid)/gentamicin sulfate composite coatings on AZ31 alloy. Surf. Coat. Technol. 2016, 291, 7–14. [Google Scholar] [CrossRef]
- Yu, X.; Ibrahim, M.; Lu, S.; Yang, H.; Tan, L.; Yang, K. MgCu coating on Ti6Al4V alloy for orthopedic application. Mater. Lett. 2018, 233, 35–38. [Google Scholar] [CrossRef]
- Fukumoto, S.; Sugahara, K.; Yamamoto, A.; Tsubakino, H. Improvement of corrosion resistance and adhesion of coating layer for magnesium alloy coated with high purity magnesium. Mater. Trans. 2003, 44, 518–523. [Google Scholar] [CrossRef]
- Tsubakino, H.; Yamamoto, A.; Fukumoto, S.; Watanabe, A.; Sugahara, K.; Inoue, H. High-purity magnesium coating on magnesium alloys by vapor deposition technique for improving corrosion resistance. Mater. Trans. 2003, 44, 504–510. [Google Scholar] [CrossRef]
- Salunke, P.; Shanov, V.; Witte, F. High purity biodegradable magnesium coating for implant application. Mater. Sci. Eng. B 2011, 176, 1711–1717. [Google Scholar] [CrossRef]
- Li, X.; Gao, P.; Wan, P.; Pei, Y.; Shi, L.; Fan, B.; Shen, C.; Xiao, X.; Yang, K.; Guo, Z. Novel Bio-functional Magnesium Coating on Porous Ti6Al4V Orthopaedic Implants: In vitro and In vivo Study. Sci. Rep. 2017, 7, 40755. [Google Scholar] [CrossRef] [PubMed] [Green Version]
- Yamamoto, A.; Watanabe, A.; Sugahara, K.; Fukumoto, S.; Tsubakino, H. Platform Science and Technology for Advanced Magnesium Alloys. Deposition Coating of Magnesium Alloys with Pure Magnesium. Mater. Trans. 2001, 42, 1237–1242. [Google Scholar] [CrossRef] [Green Version]
- Abaricia, J.O.; Farzad, N.; Heath, T.J.; Simmons, J.; Morandini, L.; Olivares-Navarrete, R. Control of innate immune response by biomaterial surface topography, energy, and stiffness. Acta Biomater. 2021, 4, 21. [Google Scholar] [CrossRef]
- Porrelli, D.; Mardirossian, M.; Crapisi, N.; Urban, M.; Ulian, N.A.; Bevilacqua, L.; Turco, G.; Maglione, M. Polyetheretherketone and titanium surface treatments to modify roughness and wettability—Improvement of bioactivity and antibacterial properties. J. Mater. Sci. Technol. 2021, 95, 213–224. [Google Scholar] [CrossRef]
- Ding Kwok, S.C.H.; Ha, P.C.T.; McKenzie, D.R.; Bilek, M.M.M.; Chu, P.K. Biocompatibility of calcium and phosphorus doped diamond-like carbon thin films synthesized by plasma immersion ion implantation and deposition. Diam. Relat. Mater. 2006, 15, 893–897. [Google Scholar] [CrossRef]
- Harnett, E.M.; Alderman, J.; Wood, T. The surface energy of various biomaterials coated with adhesion molecules used in cell culture. Colloids Surf. B Biointerfaces 2007, 55, 90–97. [Google Scholar] [CrossRef]

Publisher’s Note: MDPI stays neutral with regard to jurisdictional claims in published maps and institutional affiliations. |
© 2021 by the authors. Licensee MDPI, Basel, Switzerland. This article is an open access article distributed under the terms and conditions of the Creative Commons Attribution (CC BY) license (https://creativecommons.org/licenses/by/4.0/).
Share and Cite
Ji, Y.; Yu, X.; Zhu, H. Fabrication of Mg Coating on PEEK and Antibacterial Evaluation for Bone Application. Coatings 2021, 11, 1010. https://doi.org/10.3390/coatings11081010
Ji Y, Yu X, Zhu H. Fabrication of Mg Coating on PEEK and Antibacterial Evaluation for Bone Application. Coatings. 2021; 11(8):1010. https://doi.org/10.3390/coatings11081010
Chicago/Turabian StyleJi, Yang, Xiaoming Yu, and Hao Zhu. 2021. "Fabrication of Mg Coating on PEEK and Antibacterial Evaluation for Bone Application" Coatings 11, no. 8: 1010. https://doi.org/10.3390/coatings11081010
APA StyleJi, Y., Yu, X., & Zhu, H. (2021). Fabrication of Mg Coating on PEEK and Antibacterial Evaluation for Bone Application. Coatings, 11(8), 1010. https://doi.org/10.3390/coatings11081010

